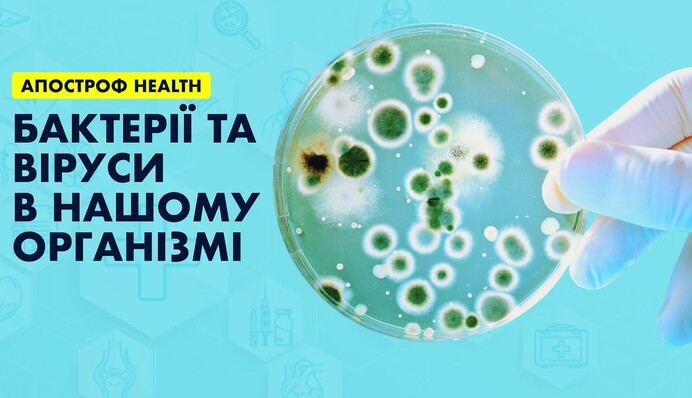
Бактерии и вирусы в жизни человека: как защитить себя от опасной угрозы

Бактерии и вирусы сопровождают нас повсюду в нашей жизни. Многолетний опыт показывает, что сосуществование человека с некоторыми вирусами и бактериями возможно лишь с вакцинацией.
Как вирус попадает в наш организм? Как работает коллективный иммунитет? Почему необходимо прививаться? Как защитить свой организм от опасных болезней? Возможна ли в Украине вспышка кори? Когда украинцы получат коллективный иммунитет от COVID-19?
Ответы на эти вопросы в эфире программы Апостроф HEALTH на Апостроф TV дал врач высшей категории, инфекционист-гепатолог, кандидат медицинских наук Виталий Янченко.